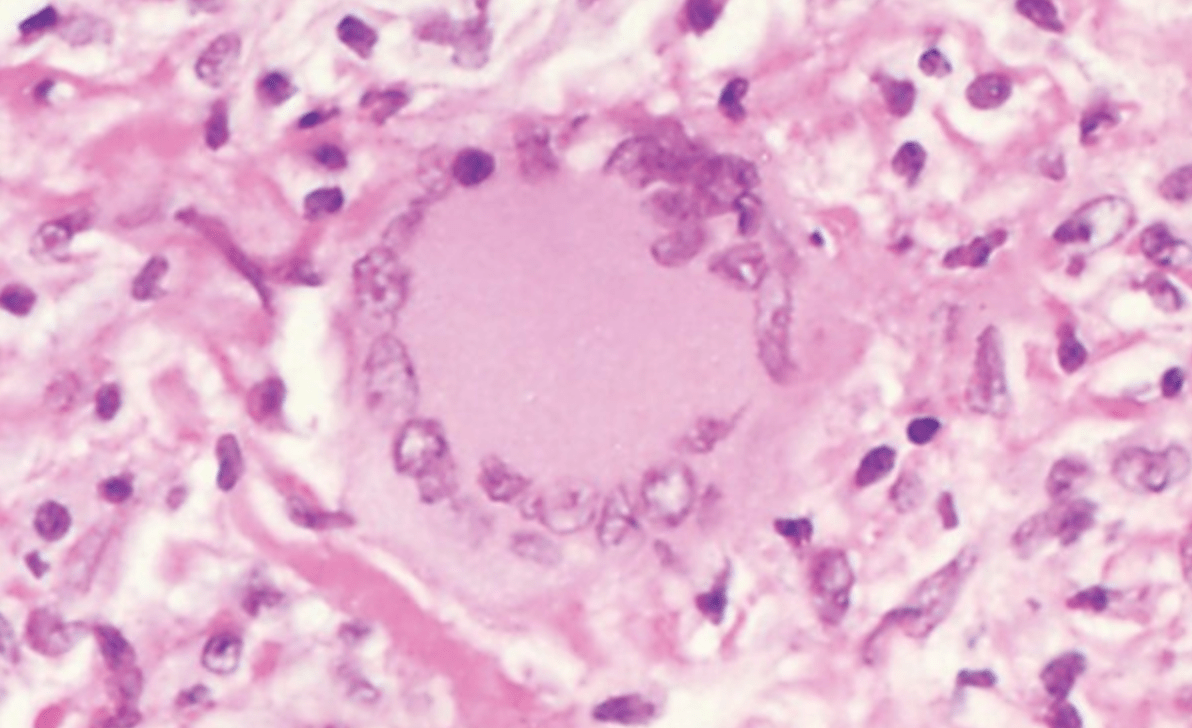

62-year-old man. Endorsing foreign body sensation, photophobia x4 days. Vision is 20/20 OU. Diagnosis?

BONUS RELATED (so following answer):
Acute hemorrhagic conjunctivitis -- Enterovirus 70, coxsackievirus A24, adenovirus 11
NOTE: If the CT Orbits shows eyelid edema, it does NOT mean preseptal cellulitis.... @hospitalists
What property of adenoviruses make them resistant to certain forms of disinfection (e.g. wiping the tonometer tip with alcohol at BSW in resident clinic...)?
BONUS: Absence of viral envelope. Envelopes comprised of lipids and proteins, which make them more susceptible to breakdown. Adenoviruses surrounded by capsid of glycoproteins, which are intrinsically more resistant.

68-year-old man is POW1 following CEIOL OS by a PGY4 resident from UT-Austin. Visual acuity is 20/100. OCT Macula reveals the following. What is the diagnosis?

BONUS: He underwent CEIOL OD two years prior and previously had excellent BCVA. However, he recently suffered acute vision loss there as well. You perform a DFE but are unable to visualize the posterior pole due to dense asteroid hyalosis. Best next step in management?
Photopic retinopathy due to extended OR time. Poor UT-Austin residents.
BONUS: Fluorescein angiography to reveal what's going on
Name at least four (4) different ways in which glaucoma / elevated IOP can be secondary to an intraocular tumor. +200 if you can name all five listed in the book.
BONUS: Among all retinal surgeries/ procedures, which is most likely to produce angle closure secondary to AR-CB?
Direct invasion of the angle, neovascularization of the angle, tumor cells obstructing the angle, intraocular hemorrhage, anterior rotation of the ciliary body.
BONUS: Scleral buckle: impedes vortex veins --> ciliary body congestion / edema --> anterior rotation of ciliary body.
What type of cell(s) is/are shown centrally here (specific pls)? How you know?

BONUS: How 'bout dis (pls be specific)?
Teuton giant cell -- multinucleated giant cell surrounded by foamy, lipid-filled outer ring.
BONUS: Langhans giant cell -- peripherally arranged nuclei in horseshoe configuration
+200 if all correct. Name every child in this program (including the interns).
BONUS: Name all of Dr. Recko and Dr. Moore's kids.
Hansens - Lavendar, Opal, Finn
Busco - Kallum
Buchanans - Damon
Johnsons - Rice Recko
McMillan - Ella and Lucy
Broxton - Brooks
Robertson - Everley, Lincoln, Annabelle, Bennett, TBD
What stage of MMP is shown below?

BONUS: Why is the cornea clear whereas the sclera is not?
Stage 3 - Symblepharon formation

BONUS: Corneal collagen fibers are the same density and diameter while the collagen fibers in the sclera are not/ disorganized. Also, sclera is hydrated while cornea is not, per Dr. Fung.

What are the three (3) primary reasons for the use of cycloplegics, particularly anti-muscarinic drops (atropine), in the management of acute uveitis (yes, you must get my three, in particular)?
BONUS (unrelated): What visual field defect is most commonly associated with cancer-associated retinopathy (CAR)?
1. Prevent the development of and/or break synechiae
2. Relieve ciliary spasm / photophobia
3. Stabilize blood-aqueous barrier. Decreases permeability (M3 receptors, in particular, responsible for increasing permeability in uveitis. Blocked by anti-muscarinic drops).
BONUS:
Ring scotoma

56-year-old male presents with acute neck pain and ptosis following a maintenance chiropractic appointment. Pupils are unequal (3 mm OD and 4 mm OS). Patient notes he has a severe allergy to iodinated contrast. What is the best means of diagnosing his condition?
BONUS (unrelated): Please provide the pathway for the pupillary light reflex.
MRI/ MRA - due to allergy
Light --> optic chiasm --> optic tract --> pretectal nucleus at level of superior colliculus --> ipsi- and contralateral Edinger-Westphal nucleus --> PREganglionic fibers leave and synapse at CILIARY ganglion

Congrats. You know the difference between a choristoma and a hamartoma. Please give an example of each (not allowed to have hamartoma in the name).
Hamartoma = capillary hemangioma, cavernous venous malformation/ orbital cavernous hemangioma, retinal capillary hemangioma
Choristoma = limbal dermoid, orbital dermoid cyst
CLASSIC LITERATURE:
Name the book and author: "It was the best of times, it was the worst of times, it was the age of wisdom, it was the age of foolishness, it was the epoch of belief, it was the epoch of incredulity, it was the season of light, it was the season of darkness, it was the spring of hope, it was the winter of despair."
BONUS (+400): Is there a Christ figure in the book (hint - yes)? If so, briefly explain what happens in the book!
A Tale of Two Cities by Charles Dickens
BONUS: Sydney volunteers to take the place of Charles Darnay at the guillotine (substitutionary atonement)!
"it is a far, far better thing that I do, than I have ever done; it is a far, far better rest that I go to than I have ever known"
"Greater love has no one than this, that one lay down his life for his friends"
-John 15:13
48-year-old female who has been seen for many years by Dr. Morrison. Referred due to corneal appearance. Pt with minimal subjective complaints aside from mild irritation. What is the most likely etiology of her complaint (you can ask a couple follow-up questions if you wish)?

BONUS: What is the histopathologic hallmark of limbal stem cell deficiency?
Limbal stem cell deficiency secondary to contact lens use (30+ years)
BONUS: Conjunctivalization - specifically, the presence of conjunctival goblet cells along with conj epithelium.
What percentage of T1DM patients will have some degree of diabetic retinopathy at 20 years or more after diagnosis (within 2%, per Wisconsin Epidemiologic Study of Diabetic Retinopathy - WESDR from 1980-2005)?
BONUS: What percentage of T1DM had PDR after 20 years?
Nearly 99% in T1DM. About 60% in T2DM.
BONUS: 50% with PDR after 20 years of T1DM. 25% for patients with T2DM.
Notable: Rates of progression have decreased with improved management of DM #Encouraging
Explain the anatomy of this angle. What happened to cause this? Best initial management?

GONIOSCOPY GUNNER: What is being visualized that is out of the norm in the photo below?
BONUS BRUH: 48-year-old woman with elevated IOP. Gonioscopy reveals the following. What is the best initial step in management (aside from lowering IOP)? Why?

Angle recession secondary to tear in ciliary body between the longitudinal and circular ciliary muscles; start aqueous suppressants / prostaglandin analogues no differently. Role of SLT less clear, although worth a shot if the gtts insufficient.
GUNNER: Glistening scleral spur in cyclodialysis cleft
BONUS BRUH: Patent LPI is actually part of diagnostic criteria for plateau iris syndrome (you can, however, have plateau iris configuration without an LPI).
But patent LPI with persistent iridotrabecular contact required to diagnose the syndrome (along with deep central AC and narrow angle from anterior ciliary body rotation)
Generally, fine-needle aspiration biopsies do NOT significantly increase the risk of seeding a tumor of the eye. What is the EXCEPTION to this generality?
Retinoblastoma
BONUS: Straight outta OQ

Retinoblastoma can be spread by FNAB.
Credit to Zach U for finding this gem from House https://www.youtube.com/watch?v=gD2_nAimvdU

BONUS: Michel (Me-shell) fixative to test for immunofluorescence (MMP)
Bryce Young threw for 448 yards against the Falcons this past Sunday. Whose record did he break?
BONUS (+200 each) - Open to switching if PGY3s choose: Which players recorded the highest receiving yards and rushing yards in a Panthers game?
Cam Newton (432 yards) vs Green Bay (2011) - Chris was present :')
BONUS:
Rushing - DeAngelo Williams - 210 yards in 2012
Receiving - Steve Smith - 201 yards in 2005
19-year-old patient with anorexia nervosa presents with 4+ PEEs OU. You diagnose her with severe dry eye. Which component of the patient's tear film is most likely deficient and why?
BONUS (+200): What other corneal/ conjunctival finding might you expect to find?
Mucin layer - Vitamin A deficiency; "associated with the loss of mucin production by goblet cells"

What is the likely underlying cause of a BRVO that does NOT occur at an AV crossing?
BONUS (+200 or 300 depending on depth): What differentiates an ischemic CRVO vs a non-ischemic CRVO
Underlying retinochoroiditis or retinal vasculitis
BONUS: ischemic CRVO shows more than 10 disc areas of capillary nonperfusion, versus less than 10 in non-ischemic CRVO. Poorer vision in ischemic. High likelihood of NV in ischemic (50-60%)
60-year-old fell from his roof and has been complaining of diplopia ever since. On Double Maddox Rod testing, you note he has 20 degrees of excyclotorsion between both eyes. He additionally has a RHT on left gaze and a LHT on right gaze. What horizontal deviation pattern may be present (i.e. XT vs ET / A-pattern vs V-pattern)?
BONUS: What is the cardinal feature (and most sensitive finding) of internuclear ophthalmoplegia?
Bilateral CN IV palsy (consider after trauma). Crossed hypertropia and large-angle excyclotorsion are common. Large V-pattern esotropia.
Makes sense given decreased ability to depress in adduction and compensatory IO overaction.
BONUS: Decreased saccadic velocity on adduction ipsilateral to the lesion. NOT abducting nystagmus contralateral (less frequently seen)
Immunohistochemical Stains Can Be Fun! (+150 each)
- HMB-45?
- S-100?
- CD20, CD3?
- Chromogranin and synaptophysin?
- Glial fibrillary acidic protein (GFAP)?
- Desmin/ myogenin?
- HMB-45 = melanoma/ melanocytic tumors
- S-100 = schwannoma (and melanoma)
- CD3, CD20, etc = lymphoma
- Chromogranin = neuroendocrine tumors (e.g. small cell lung carcinoma, carcinoid tumors in GI from med school)
- GFAP = optic nerve glioma
- Desmin = rhabdomyosarcoma
Andrew Jackson's Presidency was marked by tumult and significant events. Please list at least two major events in his Presidency (will also accept one event from his life writ large if we're struggling).
BONUS: Who was the President before OR after Andrew Jackson (+250 each)
1. Defied the Justice Marshall and the Supreme Court's ruling. Refused to enforce ruling, so Georgia continued with the Trail of Tears / Congress' Indian Removal Act of 1830
2. Destruction of the Bank of the United States
3. Avoided the Nullification Crisis (SC nearly seceded)
4. Petticoat Affair: Forced all his cabinet to resign due to their wives' refusal to welcome Margaret Eaton into their social circle in Washington, DC (long story tbh)
5. Financial Crisis of 1836
Expanded the powers of the Presidency to a remarkable extent. Populist. Congress used to have more control. Hero of FDR, Teddy Roosevelt, and Woodrow Wilson.
Life Events: Hero of the battle of New Orleans, survived duel with bullet lodged in his chest
What is the primary exam finding that differentiates a conjunctival nevus from PAM (+250)?
What other relevant clinical information and exam findings would support one diagnosis vs the other (+250)?
BOOGIE BONUS (+250): When is the removal of PAM indicated for histopathologic diagnosis?
BOOGIE OOGIE OOGIE BONUS (+250): What factors make PAM more likely to progress/ portend a worse prognosis?
Epithelial inclusion cysts present in 50% of conj nevi whereas they're practically never in PAM. HIGHLY suggestive of nevus.
Demographics/ history: Conj nevus develops in childhood - early adulthood. PAM nearly always in middle-aged adults.
Exam findings: nevi usually well-circumscribed with slight elevation. PAM is flat, less well-defined.
BOOGIE B: "More than two clock hours of conjunctival involvement"
BOOGIE OOGIE: Most important -- cellular atypia. Palpebral, caruncular, forniceal, or eyelid margin involvement. Large size (see above).
What are four (4) fundus findings associated with pseudoxanthoma elasticum?
BONUS: What was the prior name for pseudoxanthoma elasticum prior to its current naming?
Optic disc drusen (again, PXE characterized by calcium and mineral deposition), angioid streaks, midperipheral comet lesions, Peau d'orange / diffuse RPE mottling


BONUS: Grondblad-Strandberg syndrome
What adaptive mechanism is used by patients with congenital ocular motor apraxia (+250)? Why does this work (+250)?
BONUS: What is/ are the horizontal saccadic integrators? What about vertical integrators? What is the supranuclear brainstem center for control of conjugate vertical saccadic eye movements? How about horizontal?
Head thrust -- cannot consistently generate horizontal saccadic movements. Head thrust activates the VOR to move the eyes into "extreme contraversion." Foveation occurs --> slowly move head back into more normal position.
BONUS:
-Horizontal integrator - Nucleus prepositus hypoglossi (NPH) and medial vestibular nuclei
-Supranuclear conjugate horizontal saccades: PPRF
-Vertical integrator: Interstitial nucleus of Cajal (Cajal = high)
-Supranuclear conjugate vertical saccades: Rostral interstitial nucleus of the medial longitudinal fasciculus (riMLF)
Stains On Stains On Stains (+150 each or 500 if all correct): What stains... - best guesses, don't spend too much time
- Amyloid?
- Mucopolysaccarides?
- Iron?
BOUNTIFUL BONUS (+200 each or 500 if all correct): Name a condition that can be identified by each stain.
- Von Kossa / Alizarin Red?
- Gomori methenamine silver (GMS)?
- Giemsa?
Amyloid: Congo Red
Mucopolysaccarides: Alcian blue/ Colloidal iron
Iron: Prussian blue
BONUS:
- Von Kossa / Alizarin Red: Band keratopathy from staining calcium
- Gomori methenamine silver OR Calcofluor white: Fungal keratitis
- Giemsa - Chlamydial conjunctivitis

List as many Dundie award winners and the reason for their win from Season 2 of The Office (+100 each)
BONUS: Which character was Michael credited with finding during Phyllis' wedding (Season 3)?
BONUS BONUS (+250): Please provide one quote from the character Michael found (I know you nailed the bonus)
Don't Go In There After Me: Kevin Malone
Spiciest Curry: Kelly Kapore
Hottest: Ryan Howard
Bushiest/ Busiest Beaver: Phyllis Lapin
Show Me The Money: Oscar Martinez
Longest Engagement/ Whitest Shoes: Pam Beesly
Tight-A$$: Angela Martin
Fine Work: Stanley Hudson
BONUS: Uncle Al
BONUS BONUS: "The Celtics were a great team."
"C'mon, keep it together man. I had to listen to you for like a half hour and most of that stuff went right over my head."